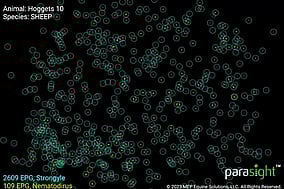

What can we help with?
Pets
We’re pet lovers. Highly trained, vastly experienced and fully devoted to caring for your special family member in our vet clinics.
Farms
Farming is what we live for. We’re specialists in production animals and lead the industry in knowledge & experience.
Equine
With some of the best known and most experienced Equine vets in Southland, we’ll make sure your horse is in the very best of health.
Get what you need now
OUR PEOPLE
Great people, great place. Start your journey with us.
We don’t provide jobs. We provide a home for the skilled, the passionate, the aspiring and the forward thinking. This is a home for those who want a sense of belonging, to be part of a community and a culture committed to science and smiles. It’s a good place. It’s home.
FURTHER READING
Latest news
We are a member of XLVets, who represent the most progressive and innovative practices in New Zealand. Our aim is to progress rural veterinary services.
Welfarm is a country wide initiative developed by XLVets in conjunction with Fonterra to measure annual welfare and productivity.
Selected carousel photos courtesy Natwick.